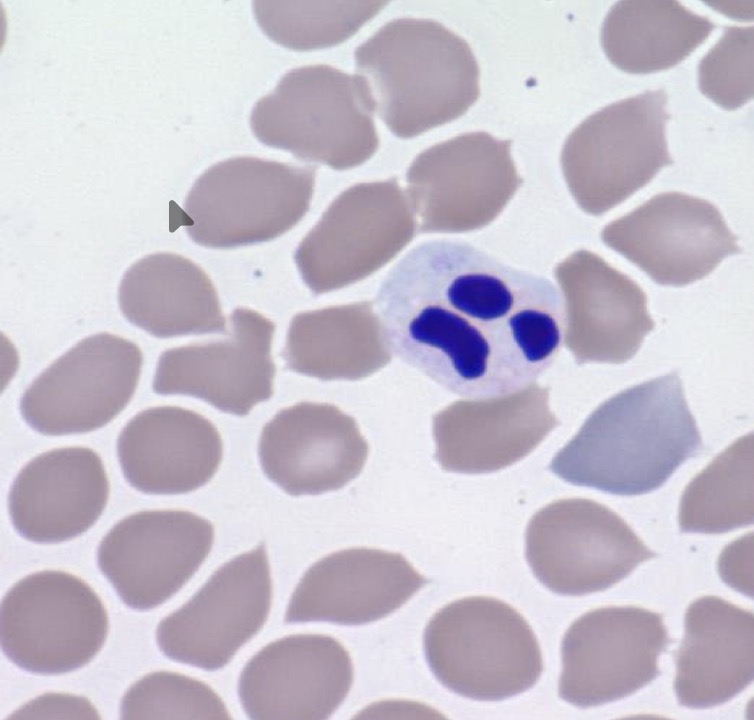
<p>Indicates non toxic enviroment</p><p>Slow progressive cellular death</p>

1/74
Looks like no tags are added yet.
Name | Mastery | Learn | Test | Matching | Spaced | Call with Kai |
|---|
No analytics yet
Send a link to your students to track their progress
What is transudate
Fluid substance that has passed through a membrane or has been forced out of a tissue
Why does transudate occur and what does it look like
due to increased pressure in tissues or low amounts of protein (low oncotic pressure) to keep fluid in vessels
Clear watery fluid
Define exudate
Fluid w high content of protein and cellular debris that has escaped from blood vessels & has been deposited in tissue or on tissue surfaces
Why does exudate happpen
Inflammation (pus)
Does transudate or exudate often clot?
Exudate clots
Transudate does not clot
What is exudate composed of
Protein and cells
What is transudate composed of
Filtered plasma w little protein and no cells
What is a chylous effusion
milky fluid produced during digestion that enters lymphatics
Uncommon
3 key tests to differentiate body fluids
protein content
Nucleated cell count
Modified transudate have higher numbers of cells and protein due to being more chronic
When measuring protein content what do we use?
Refractometer
Example of a table comparing transudate and exudates

What are some conditions that would produce transudates (4)
Possibly:
hypoproteinemia, live disease, heart disease, tumor
Possible conditions that would produce modified transudates (3)
Possibly
CHF
Abdominal tumour
Liver disease
What are some conditions that may produce exudates 5
Possibly
bleeding conditions
Bacterial infection in cavity
Chyloabdomen/chylothorax
Urine and bile peritonitis
Pancreatitis
If a cytology shows that the fluid is due to inflammation, it can lead to 1 of 2 thigns
Septic or non septic
If the cytology is non inflammatory, it can lead to 2 things
Non inflammatory= neoplastic (tumour) or non-neoplastic
If neoplastic (tumour)= benign or malignant
How much fixative should tissues be stored in when handling specimen
1 part tissue to 10 parts fixative
*10% formalin or alcohol
5 steps for specimen handling
Check before sample is collected for necessary info
Handle specimen appropriately (gloves)
Use buffered fixative for tissues
Don’t allow tissues to dry out
Seal containers
How do we dispose of formalin (formaldehyde)
Formalex
liquid that can be mixed w formaldehyde so it can be disposed into sewer system
What must be labeled on a sample? (5)
owners name
Patient name
Sample id (kidney biopsy)
Date collected
Method of collection
4 important instructions for tissue submissions to the lab
samples cant be more than 5-10mm thick
Multiple skin biopsies should be submitted in seperate containers
Protect cytology slides from formalin fumes
What should tissue submissions of tumors or skin lesions include
abnormal tissue
Border between normal and abnormal tissue
Adjacent normal tissue
*do NOT rinse tissue w water
What do we stain tissue impression smears with if vet wants margins checked
Indian ink
What is a synovial fluid cytology submission called
Joint capsule aspiration
Lymphocytes characteristic
smaller than neutrophil
Large nucleus
Most common wbc in cattle
2nd most commmon in all other species
8 most common cell types that may be seen in fluid
rbc
Neutrophil
Lymphocytes
Monocyte/macrophage
Plasma cell (B cells)
Eosinophils
Mast cells
Mesothelial cells
2 reasons for large numbers of RBC in fluid samples
Recent hemorrhage
platelets present
Associated w disease process
Erythrophagocytosis may be present
4 names of changes to the nucleus in neutrophils in fluid samples
Pyknosis
Karyorrhexis
Karyolysis
Hypersegmentation
What is pyknosis
Indicates non toxic enviroment
Slow progressive cellular death
What is karyorrhexis
Rupture of nucleus in neutrophils
weakly toxic environment

What is karyolysis
Nucleus on neutrophil stains pale
indicates rapid cell death
Highly toxic environment

What is hypersegmentation in neutrophils
More than 5 lobes in the nucleus
chronic pus forming lesions

5 toxic changes occurring in neutrophils
cytoplasmic basophil is
Toxic granulation (blue stain granules)
Toxic vacuolation (appear to have foamy cytoplasm)
Dohle bodies In cytoplasm (light blue rod shape)
Nuclear immaturity
If you see toxic changes in neutrophils, what should we also loook at?
Bacteria in cytoplasm- if present it’ll indicate septic inflammation vs non-septic inflammation
Is it common to see neutrophils in transudate
No- sometimes low #s
Possible pyknosis or hyper segmentation of nucleus
Are neutrophils common in exudate
usually large #s present
Usually indicates acute inflammatory condition
When do lymphocytes most commonly appear
Chronic inflammatory exudates
How long after acute inflammation starts do monocytes/macrophages appear
8-10hrs
What do plasma cells (b cells) indicate
Chronicity of fluid sample

What do increased numbers of eosinophils indicate
allergic reaction
Parasitic reaction
What do mast cells indicate
release histamine
During inflammatory and allergic reactions
What is the function of mesothelial cells
line bodies serous cavities (pleural, peritoneal, pericardial)
Easily mistaken for tumour cells
6 tests that should be performed on synovial fluid sample
A. Color and clarity
B. Viscosity
C. SG
D. Total Protein
E. WBC count
F. Cytology
What does viscosity testing on synovial fluid indicate
evaluates hyaluronic acid
Place drop of synovial fluid between
What is cytology?
Microscopic examination of cells from tissues, organs and body fluids
FNA
Swabs
Name an advantage of performing cytology (several)?
Rapid turnaround time
Name a potential risk/consideration of choosing to perform cytology?
Rarely, seeding of infection or neoplastic cells from the primary lesion to the surrounding healthy tissues during collection may occur.
What are 3 possible reasons for a poor-quality/non-diagnostic cytology?
hemodilution of the sample
the actual aspiration technique
slow drying of the slide
What does histopathology refer too?
microscopic examination of a piece of tissue to evaluate the cells and architecture together to help identify or rule out disease.
biopsy
more invasive
takes longer
True or False: Cytology provides a more definitive general disease diagnosis than histopathology
False, cytology does not relay information about the tissue architecture, which may affect how the cells are interpreted.
Ture or False Cytology is better for the diagnosis where identification of an individual cellular morphology is important.
True
Name three types of inflammatory cells you may see on a cytology smear (of many).
Neutrophils
Macrophages
Multinucleated giant cells
True or False: a “Purulent” inflammation contains predominantly macrophages.
False- contains predominantly neutrophils
True or False: Suppurative (purulent) inflammation may occur secondary to trauma or chemical injury (where no infection is present).
True
When evaluating a cytology sample for bacteria, to know if it’s causing the infection or not, where is an extremely important place to look?
Intracellular bacteria (look inside neutrophils) to confirm that the bacteria are pathogens.
What cells are predominantly found in each type of inflammation?
Granulomatous or Pyro-Granulomatous inflammation: Mixture of macrophages and neutrophils
Purulent inflammation: Neutrophils
What are two methods for acquiring a cytology sample (of many).
1. Fine needle aspiration (FNA)
2. Impression smear
What are two things you should do after collection to prepare a fluid sample to send out for cytologic evaluation?
Make direct smears using a sterile swab onto a glass slide immediately after collection.
Place small amount of sample in both a red top and a lavender top tube for culture and cytological evaluation.
What are three things you should do/ensure when you are preparing a solid tissue sample cytology for cytology
Blot excess fluid before doing smears
If submitting the sample for histopathology, make sure that you do not stain the sample
3. If submitting slides with tissues which have been fixed, ensure there is no leakage of formalin fumes. *formalin/glutaraldehyde fumes may alter the staining characteristics of the smear.
What are the two common stains used for cytology?
1. Romanowsky stain
2. New methylene blue
Transudate
Appearance: Clear, thin, pale yellow to colourless
Protein content: Low, <2.5 g/dl
Nucleated cell count: <1500/uL
Cell type: Lymphocytes, occasional neutrophil, some mesothelial cells, RBCs
Coagulation of fluid: None
Microorganisms: Absent
Modified transudate:
Appearance: Slightly turbid, yellow to red/reddish brown/ milky,
Protein content: 2.5 - 7.5 g/dl
Nucleated cell count: 1500/uL - 7000/uL
Cell type: Mesothelial cells, RBCs, neutrophils, macrophages
Coagulation of fluid: None to slight
Microorganisms: Absent
Exudate
Appearance: Cloudy/opaque, variable colour depending on content: red, creamy, amber or other
Protein content: >3.0 g/dl
Nucleated cell count: >7000/uL
Cell type: Neutrophils, mesothelial cells, usually RBCs, lymphocytes, macrophages.
Coagulation of fluid: Usually clots
Microorganisms: Often demonstratable
Pyknosis:
Small, round, dense staining nucleus
Karyorrhexis:
Rupture of nucleus into fromless granules
Karyolysis:
wollen, ragged nucleus that stains palely
Hypersegmentation:
>5 lobes on the nucleus
What are the 5 cytoplasmic changes that indicate immaturity/toxic change in cells?
1. Cytoplasmic Basophilia
2. Toxic Granulation
3. Toxic vacuolation
4. Dohle Bodies within the cytoplasm
5. Nuclear immaturity
True or False: There will be low numbers of neutrophils in transudate fluid.
True
True or False: With acute and chronic inflammatory exudates lymphocytes will not be seen.
False
What is the general ratio rule when it comes to adequate fixation of tissue with formalin.
10% buffered formalin is 1 part tissue to 10 parts buffered formalin.
True or False: Formalin is not carcinogenic.
False
What are five things you should put on your sample label?
1. Owner name
2. Patient name
3. Sample identification
4. Date
5. Method of collection
True or False: A sent to the lab should be no more than 5-10mm in size
False- 5-10 mm in thickness, length and breadth, can be several centimeters.
True or False: If a tissue sample is covered in blood or exudate, it is fine to rinse it off with water before examination
False- don’t rinse with water, use fixative or saline